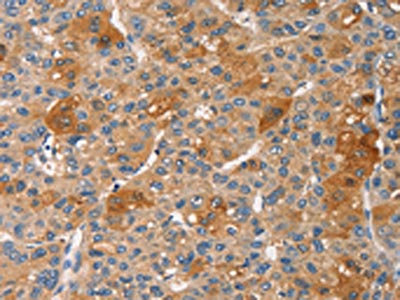

PRKCE Antibody
-
中文名稱:PRKCE兔多克隆抗體
-
貨號:CSB-PA437351
-
規格:¥1100
-
圖片:
-
The image on the left is immunohistochemistry of paraffin-embedded Human thyroid cancer tissue using CSB-PA437351(PRKCE Antibody) at dilution 1/30, on the right is treated with fusion protein. (Original magnification: ×200)
-
The image on the left is immunohistochemistry of paraffin-embedded Human liver cancer tissue using CSB-PA437351(PRKCE Antibody) at dilution 1/30, on the right is treated with fusion protein. (Original magnification: ×200)
-
-
其他:
產品詳情
-
Uniprot No.:
-
基因名:
-
別名:KPCE_HUMAN antibody; MGC125656 antibody; MGC125657 antibody; nPKC epsilon antibody; nPKC-epsilon antibody; PKCE antibody; Pkcea antibody; PRKCE antibody; Protein kinase C epsilon antibody; Protein kinase C epsilon type antibody
-
宿主:Rabbit
-
反應種屬:Human,Mouse,Rat
-
免疫原:Fusion protein of Human PRKCE
-
免疫原種屬:Homo sapiens (Human)
-
標記方式:Non-conjugated
-
抗體亞型:IgG
-
純化方式:Antigen affinity purification
-
濃度:It differs from different batches. Please contact us to confirm it.
-
保存緩沖液:-20°C, pH7.4 PBS, 0.05% NaN3, 40% Glycerol
-
產品提供形式:Liquid
-
應用范圍:ELISA,IHC
-
推薦稀釋比:
Application Recommended Dilution ELISA 1:1000-1:5000 IHC 1:50-1:200 -
Protocols:
-
儲存條件:Upon receipt, store at -20°C or -80°C. Avoid repeated freeze.
-
貨期:Basically, we can dispatch the products out in 1-3 working days after receiving your orders. Delivery time maybe differs from different purchasing way or location, please kindly consult your local distributors for specific delivery time.
-
用途:For Research Use Only. Not for use in diagnostic or therapeutic procedures.
相關產品
靶點詳情
-
功能:Calcium-independent, phospholipid- and diacylglycerol (DAG)-dependent serine/threonine-protein kinase that plays essential roles in the regulation of multiple cellular processes linked to cytoskeletal proteins, such as cell adhesion, motility, migration and cell cycle, functions in neuron growth and ion channel regulation, and is involved in immune response, cancer cell invasion and regulation of apoptosis. Mediates cell adhesion to the extracellular matrix via integrin-dependent signaling, by mediating angiotensin-2-induced activation of integrin beta-1 (ITGB1) in cardiac fibroblasts. Phosphorylates MARCKS, which phosphorylates and activates PTK2/FAK, leading to the spread of cardiomyocytes. Involved in the control of the directional transport of ITGB1 in mesenchymal cells by phosphorylating vimentin (VIM), an intermediate filament (IF) protein. In epithelial cells, associates with and phosphorylates keratin-8 (KRT8), which induces targeting of desmoplakin at desmosomes and regulates cell-cell contact. Phosphorylates IQGAP1, which binds to CDC42, mediating epithelial cell-cell detachment prior to migration. In HeLa cells, contributes to hepatocyte growth factor (HGF)-induced cell migration, and in human corneal epithelial cells, plays a critical role in wound healing after activation by HGF. During cytokinesis, forms a complex with YWHAB, which is crucial for daughter cell separation, and facilitates abscission by a mechanism which may implicate the regulation of RHOA. In cardiac myocytes, regulates myofilament function and excitation coupling at the Z-lines, where it is indirectly associated with F-actin via interaction with COPB1. During endothelin-induced cardiomyocyte hypertrophy, mediates activation of PTK2/FAK, which is critical for cardiomyocyte survival and regulation of sarcomere length. Plays a role in the pathogenesis of dilated cardiomyopathy via persistent phosphorylation of troponin I (TNNI3). Involved in nerve growth factor (NFG)-induced neurite outgrowth and neuron morphological change independently of its kinase activity, by inhibition of RHOA pathway, activation of CDC42 and cytoskeletal rearrangement. May be involved in presynaptic facilitation by mediating phorbol ester-induced synaptic potentiation. Phosphorylates gamma-aminobutyric acid receptor subunit gamma-2 (GABRG2), which reduces the response of GABA receptors to ethanol and benzodiazepines and may mediate acute tolerance to the intoxicating effects of ethanol. Upon PMA treatment, phosphorylates the capsaicin- and heat-activated cation channel TRPV1, which is required for bradykinin-induced sensitization of the heat response in nociceptive neurons. Is able to form a complex with PDLIM5 and N-type calcium channel, and may enhance channel activities and potentiates fast synaptic transmission by phosphorylating the pore-forming alpha subunit CACNA1B (CaV2.2). In prostate cancer cells, interacts with and phosphorylates STAT3, which increases DNA-binding and transcriptional activity of STAT3 and seems to be essential for prostate cancer cell invasion. Downstream of TLR4, plays an important role in the lipopolysaccharide (LPS)-induced immune response by phosphorylating and activating TICAM2/TRAM, which in turn activates the transcription factor IRF3 and subsequent cytokines production. In differentiating erythroid progenitors, is regulated by EPO and controls the protection against the TNFSF10/TRAIL-mediated apoptosis, via BCL2. May be involved in the regulation of the insulin-induced phosphorylation and activation of AKT1. Phosphorylates NLRP5/MATER and may thereby modulate AKT pathway activation in cumulus cells.
-
基因功能參考文獻:
- PKCvarepsilon directly modulates the Aurora B-dependent abscission checkpoint by phosphorylating Aurora B at S227. This phosphorylation invokes a switch in Aurora B specificity, with increased phosphorylation of a subset of target substrates, including the CPC subunit Borealin. PMID: 28004745
- Results indicate an important role of protein kinase C epsilon (PKCepsilon) in autophagy and as a therapeutic target. PMID: 29439667
- PKC epsilon, activated by DCP-LA, increases elastin and fibulin-5/DANCE in the extracellular space of cultured fibroblasts by the mechanism independent of transcriptional and translational modulation or inhibition of elastolysis. PMID: 29590645
- The downregulation of mi143 promoted cell proliferation by regulating PKCepsilon in the hepatocellular carcinoma cells. PMID: 28765889
- These results demonstrate the relevance of hepatic diacylglycerol-induced PKCepsilon activation in the pathogenesis of NAFLD-associated hepatic insulin resistance in humans. PMID: 28591572
- Data show that protein kinase C epsilon (PKCepsilon) phosphorylates migration and invasion inhibitory protein (MIIP) at Ser303 and promotes its binding to RelA/p65, facilitating colorectal cancer metastasis. PMID: 29038521
- NF-kappaB signaling thus appears to play a critical role in promoting both castration resistance and enzalutamide resistance in PKC/Twist1 signaling in prostate cancer. PMID: 28223364
- results imply that an intimate correlation between miR-218-5p and PRKCE/MDR1 axis abnormal expression is a key determinant of gemcitabine tolerance, and suggest a novel miR-218-5p-based clinical intervention target for Gallbladder cancer patients. PMID: 28492560
- Resistin-associated vascular smooth muscle cell dysfunction and intimal hyperplasia are related to PKCepsilon-dependent Nox activation and ROS generation PMID: 27573736
- PKCepsilon is a key upstream mediator in resistin-induced inflammation that may interact synergistically with TLR4 to promote NF-kB activation in macrophages. PMID: 28286252
- protein kinase C-epsilon regulation, phospholipase D1 protects retinal pigment epithelium cells from lipopolysaccharide-induced damage PMID: 27793751
- we demonstrate that PKCepsilon cooperates with the loss of the tumor suppressor Pten for the development of prostate cancer in a mouse model. Mechanistic analysis revealed that PKCe overexpression and Pten loss individually and synergistically upregulate the production of the chemokine CXCL13, which involves the transcriptional activation of the CXCL13 gene PMID: 28402859
- These results indicate that PKC promotes synaptogenesis by activating PSD-95 phosphorylation directly through JNK1 and calcium/calmodulin-dependent kinase II and also by inducing expression of PSD-95 and synaptophysin. PMID: 27330081
- epsilonPKC phosphorylation and its coevolution with ALDH2 play an important role in the regulation and protection of ALDH2 enzyme activity. PMID: 28056995
- PKCepsilon down-regulation suppresses sorting and the cancer stem-like phenotype of renal cell carcinoma 769P side population cells through the regulation of ABCB1 transporter and the PI3K/Akt, Stat3 and MAPK/ERK pathways that are dependent on the phosphorylation effects. PMID: 27037060
- PRKCE plays two major roles in cardiac muscle cells: it takes part in regulating cardiac muscle contraction via targeting the sarcomeric proteins, as well as it modulates cardiac cell energy production and metabolism by targeting cardiac mitochondria. (Review) PMID: 27312950
- PKCepsilon is a key factor for driving the formation of bone metastasis by prostate cancer cells and is a potential therapeutic target for advanced stages of the disease. PMID: 26023164
- Depletion of PKCepsilon not only enhanced HGF-induced phosphorylation of JNK and paxillin (Ser178) but also prevented c-Met degradation. PMID: 25778903
- miR-34a regulates blood-tumor barrier (BTB) function by targeting PKCepsilon; after phosphorylation, PKCepsilon is activated and contributes to regulation of the expression of tight junction-related proteins, ultimately altering BTB permeability. PMID: 25788289
- PKCepsilon-CREB-Nrf2 signalling induces HO-1 in the vascular endothelium and enhances resistance to inflammation and apoptosis. PMID: 25883219
- PKC-delta activates p38/MAPK, responsible for the inhibition of MMP-2 and -9 secretion, PKC-epsilon activates a pathway made of ERK1/2, mTOR and S6K responsible for the inhibition of NHE1 activity and cell migration. PMID: 25372487
- HepaCAM may prevent the translocation of PKCepsilon from cytosolic to particulate fractions, resulting in the inhibition of 786-0 cell proliferation. PMID: 24515280
- Knockdown of PKCepsilon expression inhibited proliferation, induced apoptosis and decreased invasiveness of human glioma cell lines, and suppressed the growth of U87 cell-derived tumors in nude mice. PKCepsilon physically interacts with Stat3. PMID: 24888992
- PKCepsilon-mediated regulation has a role in protection from loss of chromosome integrity in cells failing to resolve catenation in G2 PMID: 25483024
- Data suggest that interleukin-32alpha (IL-32alpha) associates with leukemia zinc finger (PLZF) and protein kinase c epsilon (PKCvarepsilon), and then inhibits PLZF sumoylation, resulting in suppression of the transcriptional activity of PLZF. PMID: 25178676
- IL-32alpha inhibits BCL6 SUMOylation by activating PKCepsilon, resulting in the modulation of BCL6 target genes and cellular functions of BCL6. PMID: 25245533
- Suggest distinct role of PKCepsilon in controlling cell fate and immune response of monocyte subsets. PMID: 25322815
- MicroRNA-146a controls Th1-cell differentiation of human CD4-positive T-lymphocytes by targeting PKCepsilon. PMID: 25308712
- PKC epsilon regulates the interaction between Cx43 and Kir6.1 in the cardiomyocyte mitochondria and this interaction prevents hypoxia induced cell death. PMID: 24815185
- PKCepsilon activation may have therapeutic efficacy for AD by reducing neurotoxic Abeta accumulation as well as having direct anti-apoptotic and synaptogenic effects PMID: 24848988
- RNAi silencing of Sp1 and STAT1 in breast cancer cells reduced PKC mRNA and protein expression, as well as PRKCE promoter activity. PMID: 24825907
- a novel mechanism by which a PKC-Rab5a-Rac1 axis regulates cytoskeleton remodeling and T-cell migration, both of which are central for the adaptive immune response. PMID: 24872409
- VIP regulates CFTR membrane expression and function in Calu-3 cells by increasing its interaction with NHERF1 and P-ERM in a VPAC1- and PKCepsilon-dependent manner. PMID: 24788249
- PKCepsilon activation in late passage NP cells may represent a molecular basis for aggrecan availability, as part of an PKCepsilon/ERK/CREB/AP-1-dependent transcriptional program that includes upregulation of both chondrogenic genes and microRNAs PMID: 24312401
- our results identify a novel regulatory pathway involving the interplay between ZO-1, alpha5-integrin and PKCepsilon in the late stages of mammalian cell division. PMID: 23967087
- High PRKCE expression is associated with papillary thyroid tumor development. PMID: 23457043
- Vascular endothelial tight junctions and barrier function are disrupted by 15(S)-hydroxyeicosatetraenoic acid partly via protein kinase C epsilon-mediated zona occludens-1 phosphorylation at threonine 770/772. PMID: 24338688
- activated in compressive load-cultured nucleus pulposus cells PMID: 24166186
- MiR-143 specifically targets the 3'-UTR of PRKCE and regulates its expression. PMID: 24070896
- Data indicate that small molecules that block the oncogenic addiction to PKCepsilon signaling by promoting ATF2 nuclear export, resulting in mitochondrial membrane leakage and melanoma cell death. PMID: 23589174
- PKC epsilon plays central role in mediating HGF-induced fluctuant ERK-paxillin signaling, probably via the regulation of endosomal degradation of c-Met for the migration of HepG2. PMID: 23524339
- This study identifies PKCzeta as a novel key upstream regulator of BA-regulated SHP function, revealing the role of Thr-55 phosphorylation in epigenomic regulation of liver metabolism. PMID: 23824184
- similar to Ser-428/431 (in LKB1(L)), Ser-399 (in LKB1(S)) is a PKCzeta-dependent phosphorylation site essential for nucleocytoplasmic export of LKB1(S) and consequent AMPK activation. PMID: 23612973
- Upregulation of PKCeta contributes to breast cancer cell growth and targeting either PKCepsilon or PDK1 triggers PKCeta downregulation PMID: 23562764
- Phosphorylation of serine 779 in fibroblast growth factor receptor 1 and 2 by protein kinase C(epsilon) regulates Ras/mitogen-activated protein kinase signaling and neuronal differentiation. PMID: 23564461
- Ciliated cell detachment is associated with PKCepsilon autodownregulation in bronchial epithelium. PMID: 22712879
- Studies indicate that protein kinase C isoform epsilon (PKCepsilon) is differentially regulated in erythrocyte and megakaryocyte progenitors, suggesting an addressing role toward maturation of either lineage. PMID: 23266964
- MiR-31 directly targets PRKCE and thereby suppresses NF-kappaB activity and induces apoptosis and sensitivity to anti-cancer treatments via down-regulation of BCL2 expression. PMID: 23364795
- data suggest that platelet generations produced before the acute event retain PKCepsilon-mRNA that is not down-regulated during terminal megakaryocyte differentiation. PMID: 23071564
- Report metabolic cooperation between the EGFR/PKC-epsilon/NF-kappaB pathway in PKM2 upregulation and tumorigenesis. PMID: 23123196
顯示更多
收起更多
-
亞細胞定位:Cytoplasm. Cytoplasm, cytoskeleton. Cell membrane. Cytoplasm, perinuclear region. Nucleus.
-
蛋白家族:Protein kinase superfamily, AGC Ser/Thr protein kinase family, PKC subfamily
-
組織特異性:Expressed in cumulus cells (at protein level).
-
數據庫鏈接:
Most popular with customers
-
-
YWHAB Recombinant Monoclonal Antibody
Applications: ELISA, WB, IHC, IF, FC
Species Reactivity: Human, Mouse, Rat
-
-
-
-
-
-